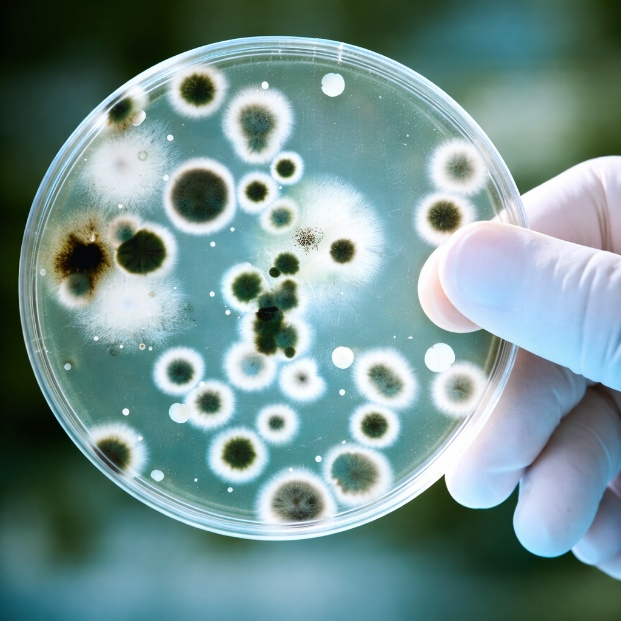
L’immagine di una piastra di Petri tenuta tra le dita di una mano con guanto da laboratorio contenente un terreno di coltura trasparente su cui sono cresciute numerose colonie di microrganismi, simbolo dell’articolo dedicato al rischio biologico, aggiornamenti e criticità della business unit EHS

Rischio Biologico: aggiornamenti e criticità

Il rischio biologico nei luoghi di lavoro è disciplinato dal Titolo X del D.Lgs. 81/2008, che definisce gli obblighi del datore di lavoro in presenza di esposizione ad agenti biologici e stabilisce le misure di prevenzione e protezione da adottare. La gestione di tale rischio non può essere affrontata in modo generico, ma richiede un’analisi strutturata e contestualizzata, fondata sulla natura dell’attività svolta e sulle modalità concrete di esposizione.
Un elemento preliminare essenziale è la distinzione tra esposizione deliberata e non deliberata. Nel primo caso l’agente biologico costituisce oggetto diretto dell’attività lavorativa, come avviene nei laboratori di analisi, nelle strutture sanitarie o nei centri di ricerca; nel secondo caso, invece, la presenza dell’agente biologico non rappresenta la finalità dell’attività, ma una possibile conseguenza delle condizioni operative, come può accadere in ambito industriale, agricolo, nella gestione dei rifiuti, negli impianti di depurazione o negli ambienti indoor dotati di ventilazione meccanica.
Gli agenti biologici comprendono virus, batteri, funghi, parassiti e, in senso più ampio, allergeni di origine biologica quali pollini, acari e insetti. La loro estrema eterogeneità, unita alla variabilità delle condizioni ambientali che ne influenzano la sopravvivenza e la proliferazione — come temperatura, umidità, presenza di materiale organico e qualità della ventilazione — rende la valutazione del rischio biologico un processo complesso. Non si tratta di un adempimento meramente formale, ma di un’analisi tecnica che richiede competenze specifiche e una conoscenza approfondita del ciclo produttivo, delle mansioni e dell’organizzazione del lavoro.
La valutazione del rischio deve partire dall’identificazione degli agenti potenzialmente presenti e dall’analisi delle modalità di esposizione, considerando le possibili vie di trasmissione, quali l’inalazione, il contatto cutaneo o mucoso, l’ingestione accidentale o l’inoculazione attraverso ferite. A ciò si affianca la valutazione della durata e della frequenza dell’esposizione, nonché delle caratteristiche della popolazione lavorativa, con particolare attenzione a eventuali condizioni di maggiore vulnerabilità. Solo integrando la probabilità di esposizione con la gravità del danno potenziale è possibile pervenire a una stima del rischio coerente e tecnicamente fondata.
La valutazione del rischio deve partire dall’identificazione degli agenti potenzialmente presenti e dall’analisi delle modalità di esposizione, considerando le possibili vie di trasmissione, quali l’inalazione, il contatto cutaneo o mucoso, l’ingestione accidentale o l’inoculazione attraverso ferite. A ciò si affianca la valutazione della durata e della frequenza dell’esposizione, nonché delle caratteristiche della popolazione lavorativa, con particolare attenzione a eventuali condizioni di maggiore vulnerabilità. Solo integrando la probabilità di esposizione con la gravità del danno potenziale è possibile pervenire a una stima del rischio coerente e tecnicamente fondata.
Il monitoraggio microbiologico rappresenta uno strumento operativo fondamentale per verificare l’adeguatezza delle misure adottate. Il campionamento può essere effettuato in modalità attiva, mediante dispositivi che aspirano un volume noto di aria su terreni di coltura specifici, consentendo una valutazione quantitativa della carica microbica, oppure in modalità passiva, attraverso la deposizione naturale dei microrganismi su piastre esposte per un tempo determinato.
Le Linee Guida ISPRA 93/2013 propongono un approccio metodologico basato sulla matrice probabilità-danno, utile per attribuire una classificazione numerica al rischio e orientare le scelte preventive. In ambito alimentare, il sistema HACCP disciplina i requisiti igienico-sanitari e può integrarsi con il Documento di Valutazione dei Rischi qualora le condizioni operative lo richiedano. Nei laboratori e nelle attività con manipolazione diretta di agenti biologici, la sorveglianza sanitaria si fonda sull’identificazione degli agenti trattati e sulla valutazione quantitativa dell’esposizione. Particolare attenzione deve essere riservata agli ambienti dotati di ventilazione forzata, nei quali gli impianti possono influire sulla diffusione o concentrazione degli agenti biologici.
La gestione del rischio biologico deve essere concepita come un processo dinamico, soggetto ad aggiornamenti periodici in relazione a modifiche organizzative, tecnologiche o ambientali. Un approccio efficace non si limita alla redazione del Documento di Valutazione dei Rischi, ma integra monitoraggi mirati, verifiche interne, formazione continua e controllo dell’effettiva applicazione delle procedure.
La complessità del rischio biologico, legata alla variabilità degli agenti e delle condizioni ambientali, impone dunque una gestione personalizzata, fondata su evidenze tecniche e su un costante riesame dell’efficacia delle misure adottate. Solo in questo modo è possibile garantire una tutela sostanziale della salute dei lavoratori, andando oltre l’adempimento formale degli obblighi normativi.
Vuoi approfondire l’argomento?
Business unit:
EHS
Tag
EHS,
Rischio Biologico,
Linee Guida ISPRA 93/2013,
Titolo X D.Lgs. 81/2008,
Salute Sicurezza


